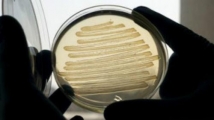

باحثون إسرائيليون يطورون مواد جديدة تسمح بالتحكم بصفات مختلفة لأشعة الضوء
تحدثت الإذاعة العبرية الناطقة بالعربية على موقعها الإلكتروني عن إنجاز علمي إسرائيلي لافت تمكنت مجموعة باحثين من معهد "التخنيون" للعلوم التطبيقية في حيفا من تطوير مواد جديدة تسمح بالتحكم بصفات مختلفة لأشعة الضوء مما قد يفسح المجال أمام تطوير منتجات حديثة في مجالات الحواسيب والبصريات والاتصالات وغيرها.
وأضافت أنه تم تجهيز المواد الجديدة بهوائيات متناهية في الصغر تستطيع حرف مسار الضوء باتجاهات مختلفة والفصل بين الأشعة الضوئية بناء على مميزاتها الفيزيائية والتحكم في مدى انبعاث الحرارة من الأجسام التي تتعرض لأشعة الضوء.





